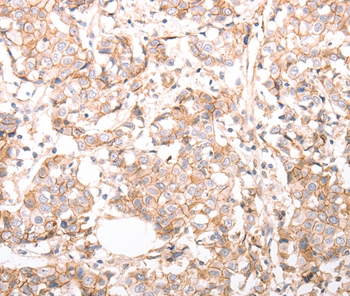
pan CDH Antibody[37301]

相关产品推荐更多 >
万千商家帮你免费找货
0 人在求购买到急需产品
- 详细信息
- 文献和实验
- 技术资料
- 免疫原:
Synthetic peptide corresponding to residues near the C terminal of human pan-cadherin
- 形态:
liquid
- 保存条件:
Store at -20˚C
- 克隆性:
Polyclonal
- 适应物种:
Human
- 保质期:
12 months
- 抗原来源:
Rabbit
- 供应商:
南京赛戈巍生物科技有限公司
- 宿主:
Rabbit
- 应用范围:
IHC
- 靶点:
Uniprot:Q9H251
- 抗体英文名:
pan CDH Antibody
- 规格:
50ul/100ul
配方:Rabbit IgG in pH7.3 PBS, 0.05% NaN3, 50% Glycerol.
应用详情:Immunohistochemistry: 1:25-1:100
图片:
Immunohistochemical analysis of paraffin-embedded Human breast cancer tissue using #37301 at dilution 1/30.
,

Immunohistochemical analysis of paraffin-embedded Human liver cancer tissue using #37301 at dilution 1/30.
风险提示:丁香通仅作为第三方平台,为商家信息发布提供平台空间。用户咨询产品时请注意保护个人信息及财产安全,合理判断,谨慎选购商品,商家和用户对交易行为负责。对于医疗器械类产品,请先查证核实企业经营资质和医疗器械产品注册证情况。
文献和实验cells infected with the 3ZF unselected library; green, mock-infected cells; stippled line, control staining without primary antibody. Genes encode: CD58 , leukocyte function-associated antigen; CDH5 , VE-cadherin (CD144); EGF , epidermal growth factor
licanming 我的实验是用VEGF处理细胞后测定细胞PKC激活水平,拟采用Western blot的方法,用ECL法检测,这样分析PKC激活程度结果国际上认可吗? 我在Cell Signaling Technology上,查到 2261 Phospho-(Ser) PKC Substrate Antibody W IP E D 9371 Phospho-PKC (pan) (betaII Ser660) Antibody W IP
【求助】谁有兔抗Paxillin和鼠抗phorsphotyrosine
-Acetylated Lysine Antibody-FITC IBN4010 Acetyl-RhoGDI (K141) Antibody IBN4011 Acetyl-PPIA (K124) Antibody IBN4005 e-Methylated Lysine Antibody IBN4008 Pan e-Trimethylysine Antibody IBN4009 Pan e-Trimethylysine Antibody-FITC IBN4003
技术资料暂无技术资料 索取技术资料





![HLA-DMB Polyclonal Antibody[31536]](https://img1.dxycdn.com/p/s14/2025/0923/305/2150219664296040791.jpg!wh200)
![Inactive phospholipase D5 Polyclonal Antibody[42664]](https://img1.dxycdn.com/p/s14/2025/0922/568/0046652811090600791.jpg!wh200)
![Bcl-2 Rabbit Polyclonal Antibody[54284]](https://img1.dxycdn.com/p/s14/2025/0922/498/0460884283108299691.jpg!wh200)
![Collagen alpha-1(IV) chain Polyclonal Conjugated Antibody[C42539]](https://img1.dxycdn.com/p/s14/2025/0923/278/4431488150116040791.jpg!wh200)
![WDFY4 Antibody[46710]](https://img1.dxycdn.com/p/s14/2025/0923/496/0462304380155040791.jpg!wh200)

